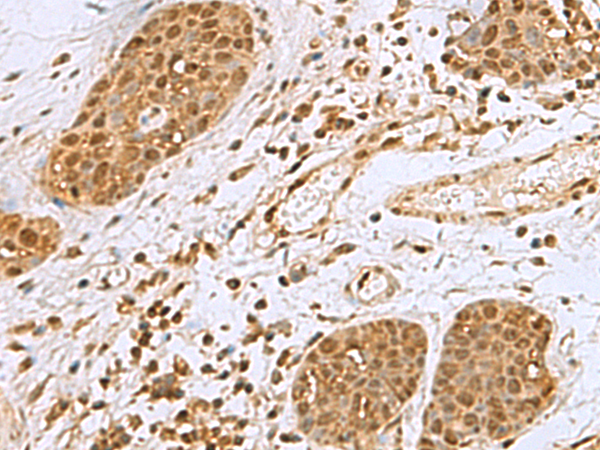

中文名稱: 兔抗NVL多克隆抗體
英文名稱: Anti-NVL rabbit polyclonal antibody
別 名: nuclear VCP-like; NVL2
相關類別: 一抗
儲 存: 冷凍(-20℃)
宿 主: Rabbit
抗 原: NVL
反應種屬: Human, Mouse
標 記 物: Unconjugate
克隆類型: rabbit polyclonal
技術規格
|
Background: |
This gene encodes a member of the AAA (ATPases associated with diverse cellular activities) superfamily. Multiple transcript variants encoding different isoforms have been found for this gene. Two encoded proteins, described as major and minor isoforms, have been localized to distinct regions of the nucleus. The largest encoded protein (major isoform) has been localized to the nucleolus and shown to participate in ribosome biosynthesis (PMID: 15469983, 16782053), while the minor isoform has been localized to the nucleoplasmin. |
|
Applications: |
ELISA, WB, IHC |
|
Name of antibody: |
NVL |
|
Immunogen: |
Fusion protein of human NVL |
|
Full name: |
nuclear VCP-like |
|
Synonyms: |
NVL2 |
|
SwissProt: |
O15381 |
|
ELISA Recommended dilution: |
5000-10000 |
|
IHC positive control: |
Human esophagus cancer and Human lung cancer |
|
IHC Recommend dilution: |
50-200 |
|
WB Predicted band size: |
95 kDa |
|
WB Positive control: |
293T and Jurkat cell lysates |
|
WB Recommended dilution: |
1000-5000 |

購物車
購物車 幫助
幫助
 021-54845833/15800441009
021-54845833/15800441009
